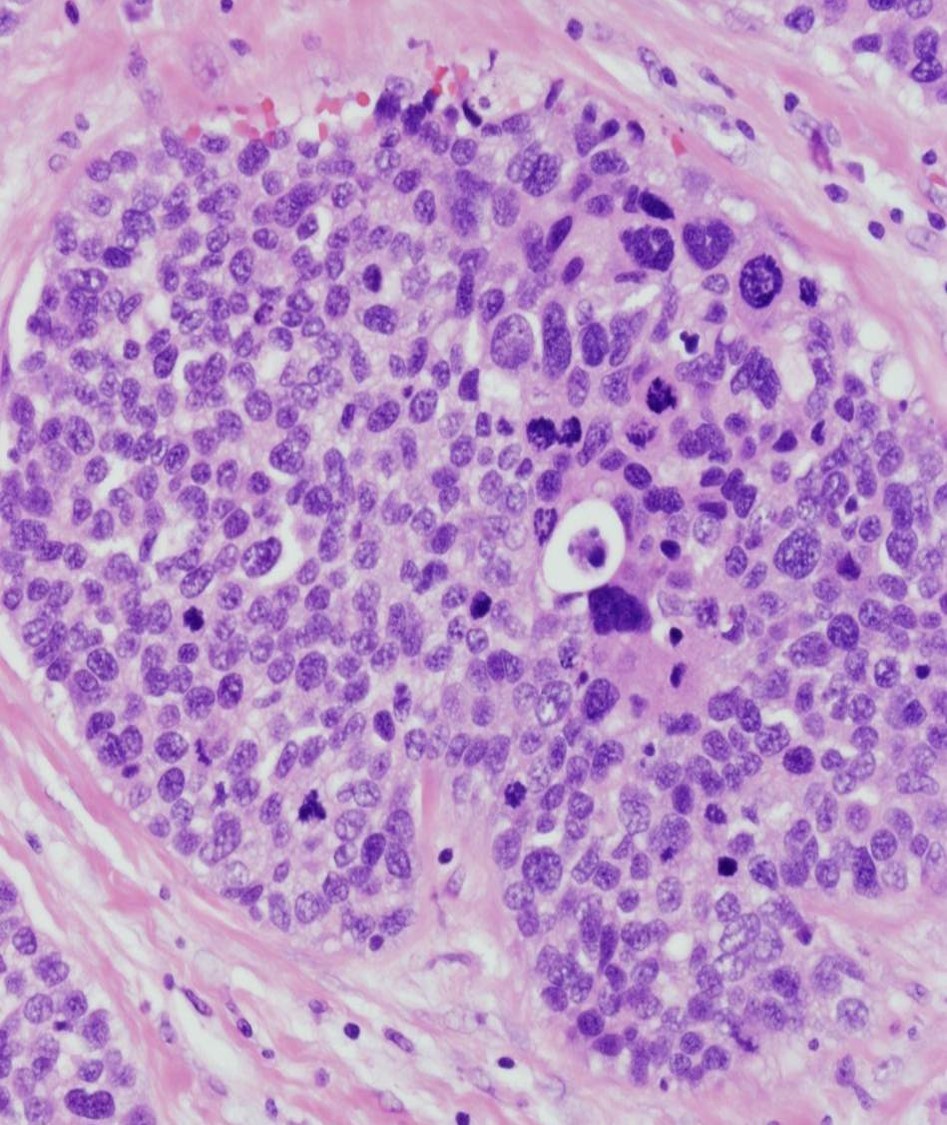

Most breast pathology arises in the ____, the area of the breast that’s composed of a terminal duct branching into a grapelike cluster of acini
lobule
Which of the following statements is FALSE?
A. The older the patient is, the more fat, and the easier it is to identify lesions on mammography
B. Ducts and acini are lined by two cell types, inner luminal epithelial cells that produce milk during lactation and outer myoepithelial cells that contract to eject it
C. Most patients that present with symptoms of breast pathology will not have cancer.
D. The most common way that patients present with breast cancer is with a palpable mass
E. Microcalcifications are an abnormal mammogram finding and may indicate the presence of tumor cells or necrotic debris
D. The most common presentation is an abnormal mammogram.
What are 3 abnormal findings in the slide shown below?

this mimics breast carcinoma, usually presenting as an abnormal mammographic finding or palpable mass, and often follows a recent history of trauma or surgery
fat necrosis; characterized acutely by necrotic adipocytes with hemorrhage and inflammation and over time will be mixed with foamy macrophages
Infection during breastfeeding causing erythema, pain, and fever
caused by fissures and cracks in the nipple that provide entry for S. aureus or Streptococci
acute mastitis
painful, erythematous subareolar mass in smokers, in which nipple ducts undergo squamous metaplasia and keratin obstructs the ductal system leading to dilatation and rupture
Squamous metaplasia of lactiferous ducts
(AKA Recurrent subareolar abscess)
(AKA periductal mastitis)
*treatment is duct excision and antibiotics
non-neoplastic enlargement of the male breast that is often painful, and is caused by an imbalance of hormones
gynecomastia
most common benign breast tumor that is well-circumscribed, slow-growing and mobile, and affects women age 20-40
fibroadenoma
*note the stromal and epithelial proliferation (below)

All of the following are findings associated with fibrocystic change EXCEPT:
A. Increased fibrosis in the breast parenchyma
B. Cyst formation
C. Apocrine metaplasia
D. Increased number of acini per lobule (adenosis)
E. Increased risk of developing breast carcinoma
E. Fibrocystic change is very common (60-80% of women) and carries no increased risk for development of carcinoma.
Which of the following statements regarding proliferative breast disease without atypia is FALSE?
A. Variety of benign lesions that are generally well-circumscribed, but carry a slightly increased risk of invasive breast carcinoma (1.5-2X)
B. Intraductal papilloma often present with blood nipple discharge
C. ductal epithelial hyperplasia shows cytologic and architectural heterogeneity but growth is limited to 2 cell layers
D. the key histologic finding of complex sclerosing lesion/radial scar is a central core of fibroelastic stroma containing trapped glands
E. With sclerosing adneosis, the breast tissue maintains its lobular architecture
C. Ductal epithelial hyperplasia is characterized by growth of >2 cell layers
note: fat necrosis, sclerosing adenosis and complex sclerosing lesion/radial scar ALL mimic breast carcinoma
Which of the following statements regarding proliferative breast disease WITH atypia is FALSE?
A. These patients are at a significant increased risk of developing breast carcinmoa (4-5x)
B. Proliferation of atypical cells shows total loss of homogeneity
C. Atypical ductal hyperplasia is most often found in biopsies done for suspicious microcalcifications in a mammogram screening
D. Atpical ductal hyperplasia differs from low grade ductal carcinoma in situ only quantitatively, in terms of the number of ducts involved
E. Atypical lobular hyperplasia is similar to lobular carcinoma in situ but fills <50% of the lobe, with loss of the e-cadherin molecule leading to poorly cohesive cells filling and expanding the acini
B. The opposite is true - proliferative breast disease WITH atypia is characterized by a proliferation of cells that look quite regular and organized
atypical ductal hyperplasia: solid and sheet like with cells that do not overlap making regular looking “punched out” spaces (see below)

Which of the following statements regarding breast carcinoma is FALSE?
A. Most breast carcinomas are HER-2 positive
B. Breast cancer affects 1 in 8 women, mostly over 40
C. White women have highest incidence of breast cancer but African-American and Hispanic women have highest mortality
D. BRCA1 and BRCA2 are both autosomal dominant mutations, which carry a 65% and 45% chance of developing breast cancer, resepctively
E. High consumption of red meat is a risk factor for breast cancer
A. Most are HER-2 negative.
A 33 year old woman presents with a discrete breast mass that is freely mobile. The MOST LIKELY diagnosis is:
A. Atypical ductal hyperplasia
B. Fibroadenoma
C. Intraductal papilloma
D. Abscess
B
All of the following are true regarding fibrocystic change EXCEPT:
A. These women have an increased risk of developing breast cancer
B. Physical examination reveals lumpy breast tissue
C. Adenosis is seen microscopically
D. It is very common
A
Which of the following statements about breast carcinoma is FALSE:
A. Mortality from breast cancer is declining
B. Physical examination may reveal a palpable mass
C. Mammographic screening is best used in women greater than 40 years of age
D. BRCA1 and 2 mutations account for 30% of breast carcinomas
D. Hereditary breast cancer accounts for ~12%
What is a histologic feature of ductal hyperplasia without atypia?
A. Monotonous cells
B. Ductal cells polarized around punched out lumina
C. Ductal cells that vary in size and shape and placement
D. Regular placement of cells
C
Which of the following statements regarding the development of breast cancer is FALSE?
A. The ER positive pathway is the most common pathway for the development of breast cancer
B. ER positive tumors are generally low grade “luminal” tumors
C. Histopathology of ER negative pathways for the development of breast cancer begin with flat epithelial atypia that progresses to atypical ductal hyperplasia and DCIS
D. BRCA1 mutations are included in ER negative pathways, while BRCA2 are see in ER positive pathways
E. Germline p53 mutations are seen in both ER negative and HER2 positive pathways
C. This is the progression seen in the ER positive pathway.
*she mentioned this was an important slide (#4 on breast path II)
Proliferation of neoplastic epithelial cells that have not invaded beyond the basement membrane of the ductal-lobular system
carcinoma in situ; does not necessarily progress to invasive carcinoma but carries a 25-30% lifetime risk;
____ disease is characterized by the spread of neoplastic cells from the ductal system into the skin of the nipple and areola, producing itchy, red, crusted, weeping lesions
paget disease; >95% of paget disease cases have underlying carcinoma

grade of DCIS that shows histology very similar to atypical ductal hyperplasia, but with more extensive ductal involvement; note the monotonous regularly spaced small nuclei, inconspicuous nucleoli and rare mitoses and NO intraluminal necrosis

low grade DCIS
grade of DCIS in which nuclei show marked variation in size, shape, and placement, prominent nucleoli and often abundant mitoses, and necrosis often present (AKA comedo type)
high grade DCIS
grade of DCIS that shows nuclei with mild to moderate variation in size, shape, and placement, variably prominent nucleoli, mitoses and intraluminal necrosis may be present (below)

intermediate grade DCIS
All of the following are true regarding the natural history and treatment of DCIS except:
A. First line treatment is mastectomy because of its 100% cure rate
B. With a partial breast excision, ~20% of women will experience recurrence
C. Partial breast excision plus radiation after surgery drops rate of recurrence to ~10%
D. Poor understanding of DCIS often results in both overtreatment and undertreatment
E. Invasive carcinoma develops in 25-30% of women with DCIS over 20-30 years time
A. Mastectomy does have a 100% cure rate, but this is often an overtreatment of women with DCIS
All of the following are true regarding lobular carcinoma in situ (LCIS) except:
A. It is usually an incidental finding on a biopsy that is done for other reasons - has no specific clinical features
B. Tends to affect postmenopausal women
C. Histo is similar to atypical lobular hyperplasia but shows more extensive involvement of the breast lobules, with more than 50% of acini distended by neoplastic cells
D. Can be differentiated from low grade DCIS by E-cadherin immunohistochemistry
E. Like DCIS, LCIS is a risk factor for invasive carcinoma (25-30%); However, unlike DCIS, the risk is almost as high in the contralateral breast as in the ipsilateral breast.
B. Mostly affects premenopausal women, with the average age of 49
*Histo shows small poorly cohesive cells with uniform round nuclei and indistinct nucleoli that fill and distend the majority of the breast lobule (below)
